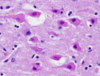

CNS Flashcards
(102 cards)
Breakdown of cytoplasmic Nissl bodies. Indicates neuronal cell injury.

Chromatolysis
These neurons are shrunken and exhibit cytoplasmic eosinophilia and nuclear pyknosis. What has caused these cell changes?
Ischemia
What is this histo of the brain showing?

Satellitosis/Neuronophagia
This pathological process can be caused by prion diseases, hepatic encephalopathy, and canine distemper virus:

Status spongiosus
Focal Symmetric Encephalomalacia is seen here with the presence of what phagocytic cells?

Gitter cells. (foamy machrophages)
What dat?

Anencephaly
What dat?

Microencephaly
Yoooo what dat?

Diprosopus (2 faces)
*Can also see synopthalmia in these cases
2 heads, 1 body, what do we call it?

Parapagus Dicephalus
Name him after his malformation (2 correct answers)

Mr. Cyclopia
Mr. Synopthalmia
This pig has meninges and cerebrum protruding through a defect in the cranium. What do we call it?

Meningoencephalocele
What’s this defect called?

Fissure
What mechanism causes this condition?

Increase in CSF.
Hydrocephalus. Can be compensatory or obstructive. Internal is the most common, where fluid accumulates in the ventricles.
This puppy presents to your clinic with seizures, exopthalmos, and ventrolateral strabismus. These are characteristic signs of what disorder?

Hydrocephalus
This guy has 2 things going on, increased CSF and the brain and meninges are protruding through the cranium. What’s the diagnosis?

Hydrocephalus and meningoencephalocele
Cases in which CSF fills the ventricles and cavitated parenchyma of the brain, although there is no gross deformation of the brain, are called ______ for small cavitations and _______ for larger cavitations.
Porencephaly; Hydranencephaly
What condition can feature an almost complete absence of the cerebral hemispheres, leaving only membranous sacs filled with CSF?
Hyranencephaly
Which viruses can lead to hydranencephaly and porencephaly when the fetus is exposed in utero?
Akabane
Bluetongue
Rift Valley Fever
BVDV
Cats and calves may present with ataxia, wide-based stance, and intention tremors as a result of exposure to which viruses in utero?

Cats: Feline Panleukopenia (parvo)
Calves: BVDV
What is the cause of spina bifida (rachischisis) in this animal?

Defective closure of the bony encasement of the spinal cord.
*May lead to meningocele or myelomeningocele
Cerebrocorticlal atrophy in this sheep is caused by an accumulation of ______ because of a lysosomal storage disease.

Lipofuscin
*Ceroid Lypofuscinosis
Betsy the cow’s favorite snack just happens to be these flowers. What lysosomal storage disease killed her?

Mannosidosis
*ingestion of locoweeds causes acquired mannosidosis. They contain inhibitors of alpha-mannosidase
Why is cerebrl edema so severe?
Leads to increased intracranial pressure (compression, ischemia, necrosis)
What is the pathological process?

Cerebral edema
(Note the cerebellar coning. Part of the cerebellum will be pushed out of the foramen magnum when intracranial pressure increases)












































